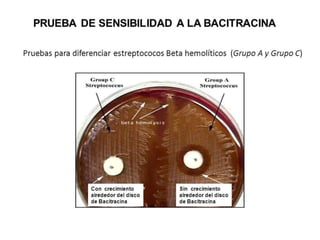
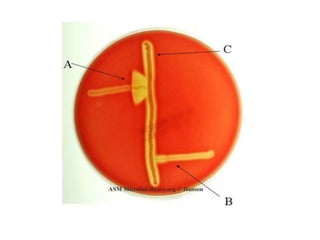

Streptococcus es un género de bacterias que incluye especies como S. pneumoniae, S. pyogenes y S. agalactiae. S. pneumoniae es un patógeno común que causa neumonía y meningitis, utilizando factores de virulencia como una cápsula polisacárida y pneumolisina. S. pyogenes causa amigdalitis y fiebre escarlatina mediante exotoxinas, mientras que S. agalactiae puede causar sepsis neonatal y meningitis neonatal a través de una cápsula y hemolisinas